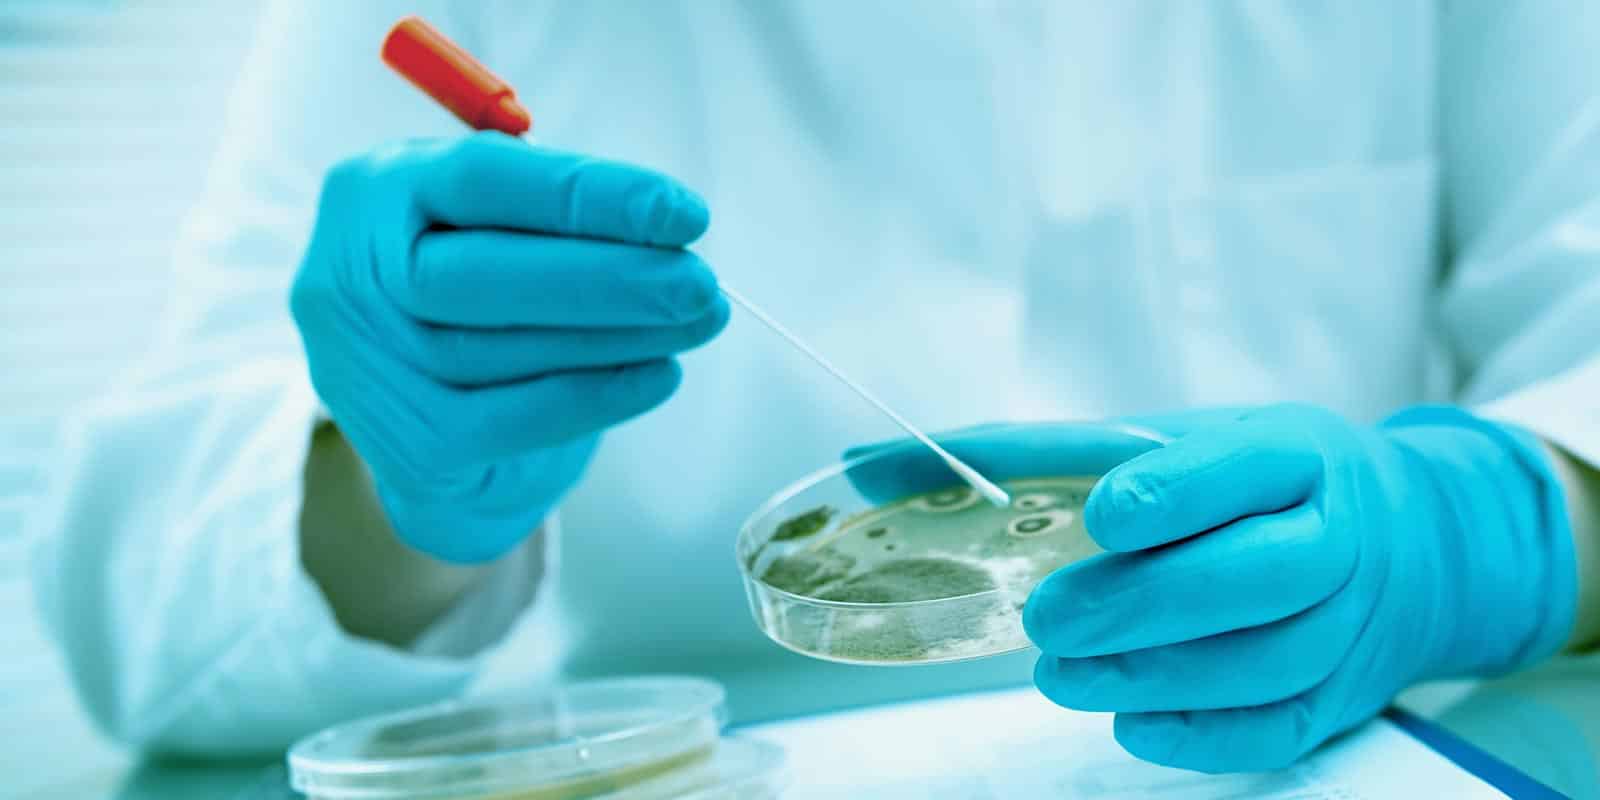

多重耐药菌(MDRO)是当前医疗机构感染防控中普遍关注的问题,其发生与传播与抗菌药物使用、诊疗行为、手卫生及环境管理等多因素相关。为梳理常见、防控中较为关键的做法,本文结合《WHO手卫生指南》、《医院隔离技术标准》、《多重耐药菌医院感染预防与控制技术指南》等权威文件综合整理,对MDRO防控要点进行归纳,供交流与参考。
![]()
识别与预警
1、高危筛查:对高风险患者,如既有MDRO定植或感染史、长期住院、长期使用抗菌药物、有气管插管或者中心静脉导管类患者进行主动筛查。
2、MRSA主动筛查常选择鼻前庭拭子,并结合肛拭子或伤口取样结果;VRE主动筛查常选择粪便、肛拭子样本;多重耐药革兰阴性菌主动筛查标本为肛拭子,并结合咽喉部、会阴部、气道内及伤口部位的标本。
3、建立预警机制:一出结果,马上通知。三方同步,立即通过信息系统、电话等方式向临床科室和医院感染管理科发出“危急值”或预警报告。
严格执行接触隔离
4、MDRO 感染或定植患者应尽量单间隔离,无单间条件时可实施同菌同室安置。严禁与留置管道、有开放伤口或免疫功能低下患者同室。
5、所有通过主动筛查发现的 MDRO 定植者,同样应按感染患者标准实施隔离,并在病房或隔离区域设置清晰的隔离标识和注意事项提示。
6、当患者隔离时,需悬挂蓝色隔离标识,标识内容应统一、明确,包括需采取的防护措施(如:需穿隔离衣、戴手套)。隔离房间内的诊疗和护理用品应实行专人专用,医务人员进出隔离区域及接触患者前后必须严格执行手卫生。
7、在进行可能产生飞沫的操作或接触分泌物、引流液、压疮、排泄物及造瘘装置时,应规范佩戴手套和隔离衣,以阻断传播途径。
8、MDRO 患者的隔离原则上持续至临床症状明显好转或治愈,部分特殊耐药菌(如耐万古霉素金黄色葡萄球菌)还需满足连续两次培养阴性方可解除隔离。

环境和设备清洁消毒原则
9、做好环境和设备清洁消毒是预防与控制多重耐药菌感染的重要措施。多重耐药感染或定植患者的诊疗环境应按《医疗机构消毒技术规范》加强清洁与消毒,重点覆盖床栏、床旁桌、监护设备等高频接触表面,并遵循“先清洁、后消毒”,被血液或体液污染时应先去除污染物再消毒,环境表面检出 MDRO 时需提高消毒频率。
10、在多重耐药菌感染的预防与控制中,共用的中低风险诊疗设备在患者使用后未能及时清洁和消毒,是导致 MDRO 传播的主要难点之一。低度危险医疗器械应尽量做到专人专用;不能专用的,如轮椅、担架、床旁心电图机等,应在每次使用后及时擦拭消毒。擦拭布巾、拖把等清洁用具应集中处理,或每日清洗消毒并干燥保存。
11、MDRO 患者诊疗过程中产生的医疗废物应按规定规范处置,患者出院或转科后必须对病房和相关环境实施终末消毒,以彻底清除残留耐药菌污染。
12、考核清洁消毒工作质量。目前存在的主要问题环境与物体表面仍存在清洁死角,部分消毒剂使用浓度不达标,影响消毒效果。应加强对保洁人员的培训与过程监管,通过荧光标记法评价清洁效果,并常规监测消毒剂使用浓度,以确保环境与物表清洁与消毒质量达标。

手卫生管理
13、手卫生是预防和控制多重耐药菌传播的核心措施,可有效阻断以接触传播为主的经手传播途径,是降低医院感染和定植风险的基础策略。医务人员应严格执行手卫生“五个时刻”,即接触患者前、清洁/无菌操作前、接触患者后、接触血液/体液后及接触患者周围环境后,均应实施规范手卫生。
14、当手部无肉眼可见污染时,应首选含醇类免洗手消毒液进行手卫生;当手部存在可见污染,或接触血液、体液后,应使用洗手液和流动水洗手,同时应强调佩戴手套不能替代手卫生。接触疑似或确诊艰难梭菌、诺如病毒及其他肠道病原体感染的患者后,应优先采用洗手液和流动水洗手。
15、医疗机构应确保手卫生设施配置充足、位置合理、方便可及,并通过持续培训、监测与反馈机制,提高医务人员手卫生依从性和规范性,将手卫生作为 MDRO 防控的常规和重点管理措施。

抗菌药物管理
16、建立并持续完善抗菌药物管理体系,加强抗菌药物分级管理、处方审核和用药监测,重点关注广谱抗菌药物、联合用药及疗程过长问题。通过临床药师参与查房、处方点评和反馈,减少不合理用药,从源头降低MDRO产生与选择压力。

质量评价及持续改进
17、防控效果的评价可通过直接指标与间接指标相结合进行:直接指标包括MDRO感染病例数、现患率、发病率及相关病死率等,反映防控成效;间接指标包括手卫生、环境清洁消毒、接触隔离、主动筛查、抗菌药物管理和培训落实情况等,体现防控措施的执行过程。医疗机构可在此基础上开展专项防控行动,运用PDCA等质量管理工具进行综合评价与持续改进,不断提升MDRO防控措施的依从性、科学性和有效性。
18、建立多学科协作体系。通过设立临床诊治组和预防管理组,分别负责MDRO病例的诊疗处置与防控措施落实,在医院感染管理部门统筹下协同运行,可有效提升耐药菌医院感染的预防与控制效果。
19、培训和宣传。培训内容涵盖MDRO相关基础知识、防控要求及手卫生、职业防护等,可采用岗前培训、继续教育和专题学习等多种形式;宣传重点在于强调医院感染与MDRO防控、抗菌药物合理使用及规范操作。
20、可通过医护人员宣教、视频播放、宣传栏、讲座及患者课堂等形式开展公众健康教育,并针对MDRO高危人群提供有针对性的指导。